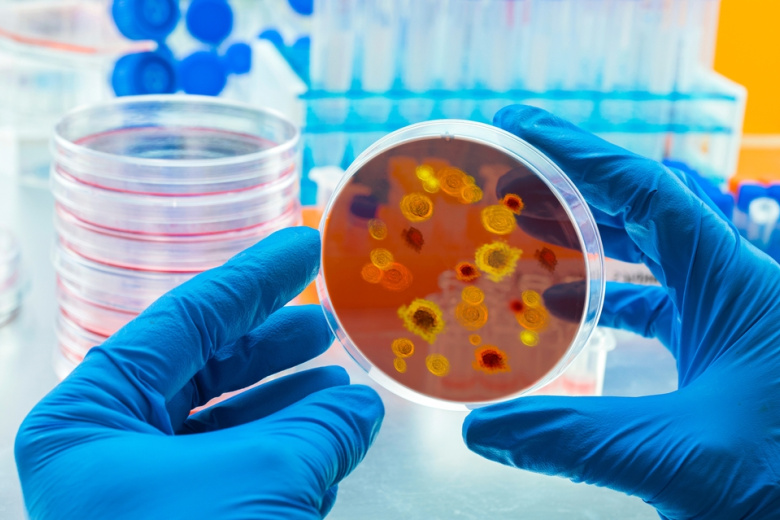

Россияне рискуют заразиться лихорадкой Денге во время путешествий по Латинской Америке и Юго-Восточной Азии, рассказал NEWS.ru профессор медфака Государственного университета просвещения хирург Дмитрий Березовский. Он отметил, что инкубационный период вирусного заболевания составляет от 3 до 14 дней.
Лихорадка Денге — вирусное заболевание, инкубационный период длится от 3 до 14 дней, а острое состояние — около недели. Первые признаки гриппоподобные: головная боль, боль в суставах, резкое повышение температуры. Среди других симптомов тошнота, рвота, диарея, увеличение лимфоузлов, сыпь — как при скарлатине. Если вы заболели вскоре после возвращения из тропического региона, лучше не ставьте себе диагноз самостоятельно, обратитесь к врачу, — заявил Березовский.
По его словам, самой опасной является геморрагическая форма лихорадки Денге — летальность составляет 1,5–23%, а наибольшему риску подвержены пожилые люди старше 60 лет. Березовский напомнил, что при такой разновидности недуга возникает кровоточивость сосудов, происходит заполнение кровью всех капилляров. В обычном же состоянии капилляры человека раскрыты, но не все одновременно, объяснил он.
Поскольку общий объем капилляров превышает объем циркулирующей крови, это вызывает нехватку питания трех главных органов, отвечающих за нашу жизнедеятельность (сердца, легких, головного мозга), и шоковое состояние. При этом геморрагическая форма, как правило, возникает при вторичном заражении, поэтому ей чаще болеют местные жители, — отметил Березовский.
Хирург подчеркнул, что заразиться лихорадкой Денге непосредственно от болеющего человека нельзя даже при близком контакте. По его словам, заболевание передается только через укусы кровососущих насекомых, являющихся переносчиками вируса. Врач посоветовал отдыхающим в тропических странах использовать репелленты.
Ранее доцент кафедры общей биологии и биоэкологии Государственного университета просвещения, кандидат биологических наук биолог Юрий Мануков заявил, что купание в водоемах, где есть карпы, может быть опасным для человека. По его словам, представители семейства карповых часто бывают заражены плоским червем из класса сосальщиков, вызывающим описторхоз.